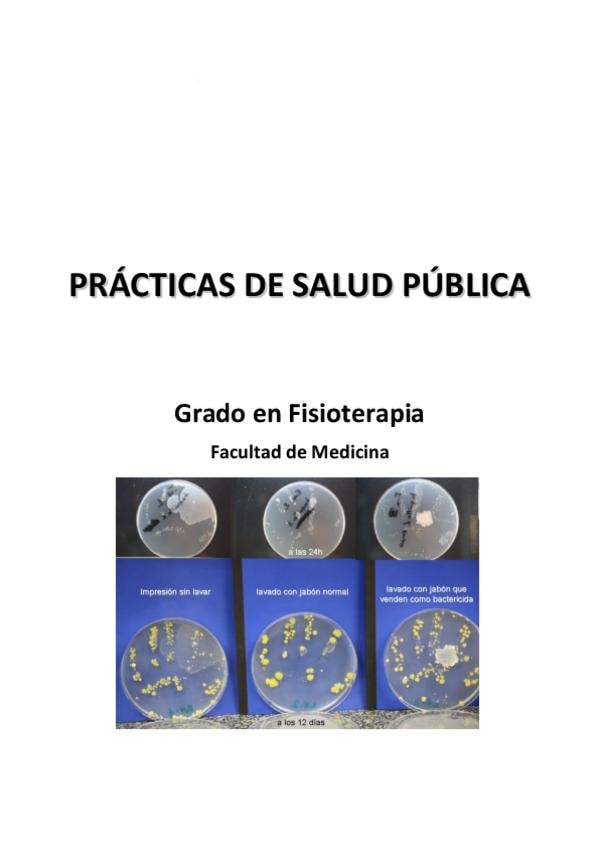

Grado en Fisioterapia (US)
Sevilla
Sube tus apuntes
arrow_forwardAsignaturas de Grado en Fisioterapia (US)
Asignatura
arrow_downward2º
•
131 posts
2º
•
53 posts
2º
•
103 posts
1º
•
212 posts
1º
•
403 posts
1º
•
166 posts
1º
•
99 posts
1º
•
169 posts
1º
•
221 posts
2º
•
144 posts
2º
•
99 posts
1º
•
234 posts
1º
•
20 posts
2º
•
286 posts
1º
•
381 posts
4º
•
26 posts
2º
•
15 posts
3º
•
33 posts
3º
•
13 posts
4º
•
49 posts
4º
•
11 posts
1º
•
160 posts
4º
•
48 posts
4º
•
95 posts
4º
•
49 posts
2º
•
27 posts
3º
•
98 posts
1º
•
198 posts
3º
•
106 posts
2º
•
164 posts
4º
•
1 posts
3º
•
3 posts
3º
•
0 posts
4º
•
5 posts
4º
•
1 posts
1º
•
87 posts
2º
•
154 posts
3º
•
12 posts
4º
•
1 posts
Últimas publicaciones de Grado en Fisioterapia (US)
apuntes
-
APUNTES 2º PARCIAL
He publicado nuevos apuntes de 2º Afecciones Médicas I: APUNTES 2º PARCIAL
He publicado nuevos apuntes de 1º Bioestadística: Tema-6.-Inferencia.pdf
He publicado nuevos apuntes de 1º Bioestadística: Tema-4.-Variable-aleatoria-y-distribuciones-de-probabilidadlah.pdf
He publicado nuevos apuntes de 1º Bioestadística: Tema-3.-Probabilidad.pdf
He publicado nuevos examenes de 3º Fisioterapia Respiratoria y Cardiovascular: PREGUNTAS-RESUELTAS-CARDIO-2026.pdf
He publicado nuevos practicas de 1º Fisioterapia General: CUADERNILLO-DE-PRACTICAS.pdf
practicas
-
Cuadernillo de Practicas
He publicado nuevos practicas de 1º Anatomia Humana Especial: Cuadernillo de Practicas
apuntes
-
apuntes pediatría
He publicado nuevos apuntes de 4º Fisioterapia Pediátrica: apuntes pediatría
apuntes
-
Neuroanatomía
He publicado nuevos apuntes de 1º Anatomia Humana Especial: Neuroanatomía
He publicado nuevos apuntes de 1º Fisioterapia General: Tema-12-helioterapia-y-climatoterapia.pdf
He publicado nuevos apuntes de 1º Fisioterapia General: Tema-11-Radiacion-infrarroja-UV-y-laser.pdf
He publicado nuevos apuntes de 1º Fisioterapia General: Tema-10-Talasoterapia-y-balneoterapia.pdf
He publicado nuevos apuntes de 1º Preparación Física: Tema-4.-Resistencia.pdf
He publicado nuevos apuntes de 4º Fisioterapia Pediátrica: Pediatría bloque VI.pdf
He publicado nuevos examenes de 2º Medicina del Desarrollo: PREGUNTAS-EXAMEN-MEDICINA-DEL-DESARROLLO..pdf
He publicado nuevos examenes de 2º Farmacología: PREGUNTAS-FARMACOLOGIA-POR-TEMAS.pdf
He publicado nuevos examenes de 2º Electroterapia: PREGUNTAS-EXAMEN-ELECTRO.pdf
He publicado nuevos examenes de 2º Afecciones Médicas I: PREGUNTAS-EXAMEN.pdf
He publicado nuevos examenes de 1º Fisiología: PREGUNTAS-FISIOLOGIA.docx
He publicado nuevos examenes de 1º Biomecánica y Física Aplicada: PREGUNTAS-EXAMEN-FISICA-APLICADA.pdf
He publicado nuevos examenes de 1º Bioquímica y Biología Molecular: PREGUNTAS-EXAMENES-BIOQUIMICA.pdf
He publicado nuevos examenes de 2º Psicología Asistencial: PREGUNTAS-MAS-FRECUENTES-PSICOLOGIA.pdf
He publicado nuevos examenes de 2º Fisioterapia en Atención Temprana: PREGUNTAS-ATENCION-TEMPRANA.pdf
He publicado nuevos apuntes de 2º Afecciones Quirúrgicas: RESUMEN-AFECCIONES-QUIRURGICAS.pdf
He publicado nuevos examenes de 2º Afecciones Quirúrgicas: PREGUNTAS-AFECCIONES-QUIRURGICAS.pdf
He publicado nuevos examenes de 3º Intervención de Fisioterapia en la Comunidad y Gestión en Fisioterapia: PREGUNTAS-EXAMEN.pdf
He publicado nuevos apuntes de 4º Fisioterapia Pediátrica: Pediatria Bloque V.pdf
He publicado nuevos apuntes de 1º Epidemiología y Salud Pública: INFORME-DE-LA-MICROBIOTA-HUMANA.pdf
He publicado nuevos apuntes de 2º Fisioterapia por Estímulos Reflejos: UNIDAD-5-INTRODUCCION-AL-EJERCICIO-TERAPEUTICO-1.pdf
He publicado nuevos apuntes de 2º Fisioterapia por Estímulos Reflejos: UNIDAD-4-EJERCICIO-TERAPEUTICO-COMPLETOS.pdf
He publicado nuevos apuntes de 2º Fisioterapia por Estímulos Reflejos: UNIDAD-3-EJERCICIO-TERAPEUTICO.pdf
He publicado nuevos apuntes de 2º Fisioterapia por Estímulos Reflejos: UNIDAD-1-MINDFULNESS-COMPLETOS-FER.pdf
He publicado nuevos apuntes de 1º Epidemiología y Salud Pública: GUION-PRACTICAS-DE-Micro-Salud-Publica.pdf
He publicado nuevos apuntes de 1º Anatomia Humana Especial: Cerebro-de-un-cerdo.pdf
apuntes
-
APUNTES PREPARACIÓN FÍSICA
He publicado nuevos apuntes de 1º Preparación Física: APUNTES PREPARACIÓN FÍSICA
Composición de preguntas de examen de anatomía especial del Miembro inferior.
He publicado nuevos apuntes de 4º Fisioterapia Pediátrica: Pediatria bloque IV.pdf
He publicado nuevos apuntes de 1º Preparación Física: tema-3-preparacion-fisica.pdf
He publicado nuevos apuntes de 1º Preparación Física: tema-2-preparacion-fisica.pdf
He publicado nuevos apuntes de 1º Preparación Física: tema-1-preparacion-fisica.pdf
He publicado nuevos apuntes de 1º Fisioterapia General: Tema-2-El-masaje-terapeutico.pdf
He publicado nuevos apuntes de 1º Fisioterapia General: Tema-3-Tecnicas-especiales-de-masoterapia.pdf
He publicado nuevos apuntes de 1º Fisioterapia General: Tema-7-Crioterapia.pdf
He publicado nuevos apuntes de 1º Fisioterapia General: Tema-8-Hidroterapia.pdf
He publicado nuevos apuntes de 4º Fisioterapia Pediátrica: Pediatría bloque III.pdf
He publicado nuevos apuntes de 1º Fisioterapia General: Tema-4-Cinesiterapia.pdf
He publicado nuevos apuntes de 1º Preparación Física: PREPARACION-FISICA-T.-1-2-3 (1ª-parte).pdf.pdf
He publicado nuevos apuntes de 1º Preparación Física: Tema-3.I-La-fuerza.pdf
He publicado nuevos apuntes de 1º Bioestadística: Tema-1-Estadistica-descriptiva.pdf
He publicado nuevos apuntes de 1º Bioestadística: Tema-2-Series-de-dos-variables.pdf
He publicado nuevos apuntes de 4º Fisioterapia Pediátrica: Pediatria bloque II.pdf
He publicado nuevos apuntes de 4º Fisioterapia Pediátrica: Pediatría-bloque- I .pdf.pdf